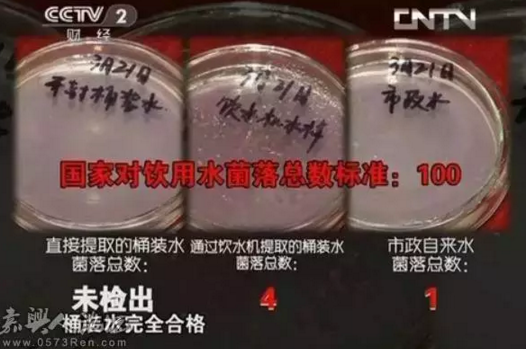

令人吓到怀孕的桶装水,直饮水机你该装了
圣蓝健康直饮机有限公司网上有传言称,桶装矿泉水开封3天后,比自来水里的细菌还要多得多,这是真的吗? 有媒体与医院人士进行了相关测验,不测不知道,一测吓一跳!
水样调取:
1、直接提取的桶装水
2、通过饮水机提取的桶装水
3、市政自来水
48小时过后,得到如下检测结果:
1、 三天后,对同样的桶装水样进行检测,从饮水机提取的桶装水检测结果如下:

2、三天后, 对同样的桶装水样进行检测,直接提取桶装水,不经过饮水机检测结果如下:

总结:同样是三天后,直接提取的桶装水与从饮水机提取的桶装水,细菌总数相差很大! 可见饮水机才是繁殖细菌的最大元凶!
专家建议:在日常使用过程中,最好对饮水机进行清洗消毒,并且在选择时最好能选择三天后能饮用完的小容量产品。
通过饮水机提取开封三天后的桶装水前,将饮水机调到加热状态,在饮水机加热到最高温度后,从热水口接出另一瓶水样,待冷却后进行检测,检测结果表明:同样是开封三天后的桶装水,经加热后未检出菌落!

1、如果按日常饮用方式,通过饮水机接出的桶装水,开封三天后的细菌含量比开封当天连翻227倍!甚至远远超过国家对饮用水细菌总量的标准; 但若对其加热烧开,细菌就会被全部杀死,再次回到安全饮用状态。

2、即使排除饮水机的污染,直接测量桶装水本身,开封三天后,细菌含量仍然超过市政自来水的菌落总量!

所以,桶装水开封三天,细菌含量远高于自来水,是真的!!
作为用水安全,就目前水质而言,还是直饮机、净水器,可以解决你的后顾之忧,更安全、更健康!看到以上这些是不是真的该买一台直饮机、净水器了?值得你做决定。

商用净水专题
校园微信支付刷卡饮水机
2019新校园刷卡广告直饮水机…
校园壁挂刷卡管线饮水机哪个牌子…
学校净水设备介绍
圣蓝智能健康直饮水机品牌优势特点
校园节能直饮水机与其他饮水方式…
校园直饮水系统工程有何特点
校园刷卡直饮水机投资项目那点事
直饮水机行业前景无限,净水行…
圣蓝校园刷卡直饮水机解决方案
河南客户再次订购校园不锈钢饮水…
浅析校园刷卡直饮水机如何获得…
校园直饮机项目投资如何成功
商用直饮水机产品价格流失的客…
校园刷卡直饮水机投资需要多少钱
2017年如何做好校园刷卡直饮…
医院不锈钢直饮机,千万别错过深…
圣蓝教你校园直饮水机投资如何少…
好的办公室直饮水机具备哪些条件
如何正确安装校园不锈钢饮水机
联系我们
全国统一服务热线:
4006-112-966

